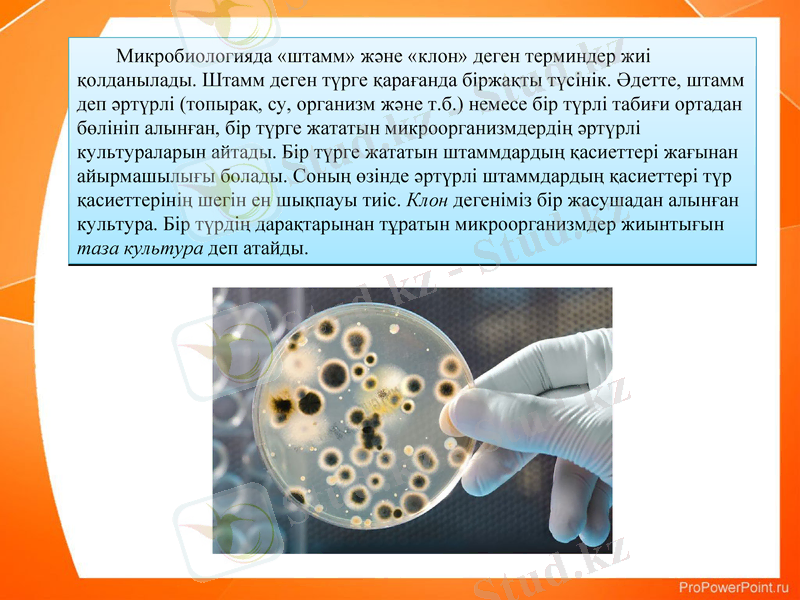
Slide 6

Бунақденелер мен кеміргіштердің бактериялық аурулары: сипаттамасы және жіктелуі



Бунақденелердің және кеміргіштердің бактериялды аурулар
Орындаған:
Қабылдаған:

Жоспар:
Кіріспе
2. 1. Бунақденелердің және кеміргіштердің бактериялды аурулары
2. 2. Бактериялы аурулардың түрлері
Қорытынды
Пайдаланылған әдебиеттер

Кіріспе
Ауыл шаруашылығы дақылдарының негізгі организмдер тобы - энтомофагтар; гербифагтар, маңызды зиянкестер патогендері мен антогонистерінің, арамшөптер мен ауру қоздырғыштарының жүйелеуін; биология мен экология негіздерін, ауыл шаруашылығы дақылдарының зиянкестері мен ауру қоздырғыштарының табиғи жауларының тиімділік дəрежелерін, саңырауқұлақтық, вирустық жəне бактериялық препараттарды алу жəне сақтау технологиясын, энтомофагтар, акарифагтар мен гербифагтарды жаппай көбейту, сақтау жəне қолдану əдістерін, биофабрикалар мен биозертхана машиналарын білу керек.
Сонымен қатар:
-зиянкестер, аурулар жəне арамшөптермен күресу үшін керекті биологиялық құралдардың қажетті мөлшерін есептеу тəсілдерін;
-оларды қолданудың биологиялық, экономикалық тиімділігін анықтай білуін;
-ауыл шаруашылығында зиянкестер, аурулар жəне арамшөптермен күресуге өсімдік өсуін реттеушілер тізімі мен қорғау жүйесін құруға керекті ақпараттарды іріктей біліп, аймақтағы энтомофагтар, акарифагтар мен микроорганизм түрлерін қорғауға, керек болғанда тиімділерін көбейтіп пайдалана білулері керек.

Бунақденелер мен кеміргіштердің ішектерінде көптеген тұрақты бактериялар болады. Бұлардың көпшілігі - зиянсыз сапрофиттер, комменсалдар, ал кейбір жағдайларда жануарларға пайдалы, маңызды симбионттар (селбесушілер) . Ішек флоралары сапрофиттерінің біраз түрлері организмге улы болуы мүмкін, қанға араласқан кезде тез көбейіп кетіп, организмді жалпы уландырып, бунақденелерді өлтіреді. Əдеттегі жағдайда олар латентті деп аталатын күйде, яғни жасырын күйде «мүлгіген, қалғыған» пішінде болып, олардың көбеюі мен қанға енуін ас қорыту сөлінің бактероцидті жəне басқа организмнің басқадай қорғаныс механизмімен бақыланады. Организмге қолайсыз жағдайда оның қорғаныс күші бəсеңдеп, ауруға шалдығады.
2. 1. Бунақденелердің және кеміргіштердің бактериялды аурулары
Зиянды бунақденелер бактериялы ауруларының бар екендігін 1879 жылы алғаш байқаған И. И. Мечников болды. Ол Украинаның оңтүстігінде астық қоңызы дернəсілінің ауруын қоздыратын бактерияны сипаттап жазды, ал Л. Пастер жібек құртының фляшерия ауру қоздырғышын анықтады. Ал Ф. Чешаир жəне У. Чейн бал арасының европа шірігі ауру қоздырғышын анықтады. Содан бері бунақденелер мен кеміргіштердің ауруын туғызатын бактериялардың жүзден артық түрлері мен түр тармақтары ашылды.

Бунақденелердің алғашқы патогендері ретінде белсенді түрде ішек қабырғалары немесе организмнің жабыны арқылы енуге қабілетті бактериялардың кездестіні белгілі. Бұлардың иелерінің ұлпалары бөлінген улар немесе ферменттердің əсерінен бактериялардың еніп, тез көбеюіне жайлы келеді. Қазіргі кезде бұлардың біразы бунақденелер мен кеміргіштерге қарсы күресу үшін зауыт жағдайында бактериялық препараттар дайындауға қолданылады. Микроорганизмдер көне заманнан бері тіршілік етіп еле жатқан жер бетіндегі тірі организмдер өкілі болып саналады. Олар 3 миллиард жыл бұрын пайда болған деген түсініктемелер бар. Бірқатар зерттеушілер микроорганизмдер ең алғаш пайда болған тірі денелер десе, басқаларының пікірінше микроорганиздерден де бұрын жасушалық пішіні жоқ организмдер (архебионттар, фотобионттар, протобионттар жəне т. б. ) тіршілік еткен деген мəлімет бар.
Микробиологияда «штамм» жəне «клон» деген терминдер жиі қолданылады. Штамм деген түрге қарағанда біржақты түсінік. Əдетте, штамм деп əртүрлі (топырақ, су, организм жəне т. б. ) немесе бір түрлі табиғи ортадан бөлініп алынған, бір түрге жататын микроорганизмдердің əртүрлі культураларын айтады. Бір түрге жататын штаммдардың қасиеттері жағынан айырмашылығы болады. Соның өзінде əртүрлі штаммдардың қасиеттері түр қасиеттерінің шегін ен шықпауы тиіс. Клон дегеніміз бір жасушадан алынған культура. Бір түрдің дарақтарынан тұратын микроорганизмдер жиынтығын таза культура деп атайды.

2. 2. Бактериялы аурулардың түрлері
Қазіргі кезде Д. Х. Бергидің «Бактериялар анықтамасының» соңғы тоғызыншы басылымы (1984) қолданылады. Мұнда барлық прокариоттық микроорганизмдер дүниесі 4 бөлімге біріктірілген. Ол бөлімдер тиісінше кластарға, қатарларға, тұқымдастарға, туыстарға жəне түрлерге бөлінеді. Микроорганизмдер негізінен олардағы жасуша қабырғасының бар- жоғына қарай жəне басқа да таксономиялық категорияларға байланысты бөлімдерге ажыратылады. Энтомопатогенді бактерияларды жіктеу үшін қосымша олардың уыттылықтарын анықтайтын жағдайлары мен қасиеттері есепке алынады.
Энтомопатогенді бактериялар 4 топқа бөлінеді:
1) облигатты патогендер;
2) криссталды спора-түзушілер;
3) факультативтілер;
4) потенциалды патогендер.

Өсімдіктерді биологиялық қорғау тұрғысынан қарағанда керекті бактериялар негізінен эубактерияларға жатады, ал риккетсиялардың тобын зерттеу енді ғана басталды.
Эубактериялар-Eubacteria. Бұлар табиғатта кең таралған жəне 3 тұқымдастардан тұрады: псевдомонадтар тұқымдасы, ішек бактериялары тұқымдасы, бациллдар немесе спора түзуші бактериялар тұқымдастары.
Псевдомонадтар (Pseudomonadaceae) тұқымдасы. Бұл тұқымдасқа спорасыз, тік немесе сəл иілген таяқша тəріздес Грам теріс бактериялар жатады. Жіпшелері жасушаның екі ұшына немесе бір шетінде орналасқан. Табиғатта кең таралған, факультативті организмдер, кейбір түрлері минералды ортада дамиды. Көптеген түрлері көк - жасыл, қызыл, күлгін түсті флуоресценсиялаушы пигменттер түзетін бактериялар. Бұл тұқымдасқа псевдомонас туысы бунақденелер потенциалды ауру қоздырғыштарының мына түрлері жатады - Pseudomonas P. aeruginosa, P. chlororaphis, P. fluorescens жəне басқалар.
Ішек бактериялары тұқымдасы. Бұл тұқымдасқа Грам теріс, қозғалатын немесе қозғалмайтын, спорасыз аэробты немесе факультативті анаэробты таяқшалар жатады. Олардың кейбір түрлері капсулалар түзеді. Бактериялардың жіпшелері перитрихальді, яғни жасуша бетін түгелдей басады. Кəдімгі қоректік ортада жақсы өседі. Бұл тұқымдасқа 12 туыс жатады, солардың ішінде міндетті, факультативті патогендер жəне сапрофиттер де кездеседі. Факультативті патогендерге жататын бактериялардың басқа туыс өкілдерінен ерекшелігі қызыл пигмент - продиогизин құрайтындығында. Осы қасиетіне қарай оны ғажайып қан таяқшасы деп те атайды.

Қауіпті ауру қоздырғыштар қатарына сальмонелл туысының өкілдері жатады. Сальмонелл кейбір тышқан тəрізді кеміргіштердің сүзек ауруын қоздырады. Осы бактерияның негізінен тышқан тəрізді кеміргіштермен күресуге пайдаланылатын бактериялы препарат дайындалады (бактероденцид) .
Бактероденцид кең түрде тышқан тəрізді кеміргіштерге (тышқандар, сұр тышқандар, сұр атжалман) қарсы кең түрде қолданылады.

Бациллдар немесе спора түзуші бактериялар тұқымдастары. Бұл тұқымдасқа температураға төзімді споралар түзетін бактериялар жатады. Тұқымдастың өкілдері түгелдей Грам теріс таяқшалар. Өсімдікті биологиялық қорғау үшін маңыздыларына Bacillus жəне Clostridium туыстарының өкілдері жатады. Бациллус туысына аэробы грам оң таяқшалар жатады. Споралары жасушаның ортасында түзіледі. Бұл жағдайда да жасуша өз пішінін жəне көлемін сақтайды. Қоректік қор ретінде жасуша ішінде май тамшылары болады. Бунақденелердің міндетті ауру қоздырғыштарының кристалл түзбейтіндерінен осы туысқа жататындары B. lentimorbus Dut. жəне B. popilliae Dut., бұлар жапон қоңызы дернəсілінің жəне басқа тақта мұрттыларының, мысалы мамыр қоңызының сүт ауруын қоздырады. Иелерінің сезімтал түрлері бактерия спораларын жұтқан соң, ие организімінде-ішегінде бактерия көбейеді. Өніп келе жатқан споралардың вегетативтік жасушалары дене қуысының біраз бөлігін толтырады. Аурудың бұл кезеңін септицемия (аурудың белгілері бір мүшені жайлауы) деп атайды. Иесі өлместен бұрын ауру қоздырғыш қалың қабырғалы сəулені сындырушы спора түзеді, ол бунақденелер сыртынан ақ сияқты болып көрінеді. Осыдан аурудың аты аталған. Осы тұқымдасқа бактериялардан Bacillus thuringiensis Berl. Бактериозы жатады. Осы бактерияның түр тармағы бунақденелерге қарсы пайдаланатын бактериялық препараттар дайындауға кең түрде қолданылады. Бактериялардың бұл тобына кристалл тəрізді ақуызды қоспалар түзу немесе параспоралды дене түзу тəн. Мұндай қоспалар, əсіресе қабыршақ қанаттыларға залалды болады

Bacillus туысына кейбір түрлерге факультативті патоген (ауру қоздырғыш) : Bacillus cereus Fr. Et Fr. жатады. Бұлар бунақденелерге улы зат С - фосфолипазаны жеткілікті мөлшерде бөлгенде олардың ішкі жасушалары бұзылып, улы зат ие денесінің қуысына енеді.
Клостридиум туысына міндетті анаэробты спора түзуші таяқшалар жатады. Бациллдардан айырмашылығы бұларда спора түзу кезінде жасуша қабырғасы қалыңдайды. Спора жасуша денесінің ортасына немесе ұшына орналасады, осыған орай жасуша пішіні ұршық тəрізді болады. Бұл туысқа бунақденелердің міндетті екі ауру қоздырғышы енеді - C. brevifaciens Buch. жəне C. malacosomae Buch.
C. brevifaciens Buch
Bacillus cereus Fr. Et Fr

Риккетсиялар - Ricketsia. Бұл бактериялардың қасиеттері мынадай: қозғалмайды, грам теріс, прокариоттарға тəн жасуша қабығы болады. Ішінде тірі ұлпалары бар арнаулы қоректік ортада өсіріледі. Бірақ бұл қасиет осы қатардың барлық өкілдеріне тəн өсіріледі. Риккетсийлер арасында қозғалғыш, Грам мен оңға боялатын, жəй қоректік орталарда өсіруге көнетін түрлері де болады. Организм мен риккетсийлер арасындағы қарым - қатынас түрліше. Олар паразиттікпен қатар мутуалистік қатынаста байқалады.

- Іс жүргізу
- Автоматтандыру, Техника
- Алғашқы әскери дайындық
- Астрономия
- Ауыл шаруашылығы
- Банк ісі
- Бизнесті бағалау
- Биология
- Бухгалтерлік іс
- Валеология
- Ветеринария
- География
- Геология, Геофизика, Геодезия
- Дін
- Ет, сүт, шарап өнімдері
- Жалпы тарих
- Жер кадастрі, Жылжымайтын мүлік
- Журналистика
- Информатика
- Кеден ісі
- Маркетинг
- Математика, Геометрия
- Медицина
- Мемлекеттік басқару
- Менеджмент
- Мұнай, Газ
- Мұрағат ісі
- Мәдениеттану
- ОБЖ (Основы безопасности жизнедеятельности)
- Педагогика
- Полиграфия
- Психология
- Салық
- Саясаттану
- Сақтандыру
- Сертификаттау, стандарттау
- Социология, Демография
- Спорт
- Статистика
- Тілтану, Филология
- Тарихи тұлғалар
- Тау-кен ісі
- Транспорт
- Туризм
- Физика
- Философия
- Халықаралық қатынастар
- Химия
- Экология, Қоршаған ортаны қорғау
- Экономика
- Экономикалық география
- Электротехника
- Қазақстан тарихы
- Қаржы
- Құрылыс
- Құқық, Криминалистика
- Әдебиет
- Өнер, музыка
- Өнеркәсіп, Өндіріс
Қазақ тілінде жазылған рефераттар, курстық жұмыстар, дипломдық жұмыстар бойынша біздің қор #1 болып табылады.



Ақпарат
Қосымша
Email: info@stud.kz